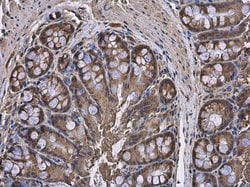

Learn More
Invitrogen™ HPRT1 Polyclonal Antibody


Rabbit Polyclonal Antibody
Supplier: Invitrogen™ PA522281
Description
Recommended positive controls: 293T, A431, HeLa, HepG2, Molt-4, Raji, mouse liver. Predicted reactivity: Rat (96%), Zebrafish (93%), Xenopus laevis (92%), Dog (96%), Pig (97%), Rabbit (98%), Chicken (94%), Chimpanzee (99%), Bovine (94%). Store product as a concentrated solution. Centrifuge briefly prior to opening the vial.
The protein is a transferase, which catalyzes conversion of hypoxanthine to inosine monophosphate and guanine to guanosine monophosphate via transfer of the 5-phosphoribosyl group from 5-phosphoribosyl 1-pyrophosphate. This enzyme plays a central role in the generation of purine nucleotides through the purine salvage pathway.
Specifications
| HPRT1 | |
| Polyclonal | |
| Unconjugated | |
| HPRT1 | |
| C81579; HGPRT; HGPRTase; HPGRT; Hprt; HPRT 1; HPRT B; Hprt1; hprt1 protein; hypoxanthine guanine phosphoribosyl transferase; hypoxanthine guanine phosphoribosyl transferase 1; hypoxanthine phosphoribosyl transferase; hypoxanthine phosphoribosyltransferase 1; hypoxanthine-guanine phosphoribosyltransferase; hypoxanthine-guanine phosphoribosyltransferase 1; id:ibd1344; id:ibd5108; testicular tissue protein Li 89; wu:fc10g09; zgc:56221; zgc:86608 | |
| Rabbit | |
| Antigen affinity chromatography | |
| RUO | |
| 15452, 24465, 3251 | |
| Store at 4°C short term. For long term storage, store at -20°C, avoiding freeze/thaw cycles. | |
| Liquid |
| Immunohistochemistry (Paraffin), Western Blot, Immunocytochemistry | |
| 1.06 mg/mL | |
| PBS with 20% glycerol and 0.025% ProClin 300; pH 7 | |
| P00492, P00493, P27605 | |
| Hprt, HPRT1 | |
| Recombinant protein encompassing a sequence within the center region of human HPRT. The exact sequence is proprietary. | |
| 100 μL | |
| Primary | |
| Human, Mouse, Rat | |
| Antibody | |
| IgG |
Safety and Handling
Your input is important to us. Please complete this form to provide feedback related to the content on this product.